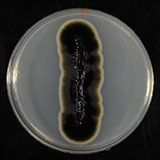
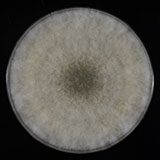
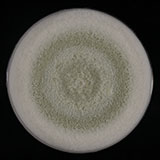
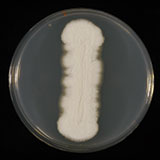

大切な住まいを汚す危険な菌
カビとは、菌類の分類群にまたがってみられる一部の姿を指し、肉眼的に観察できる集落(コロニー)の呼称です。なお、菌類は、一般用語として呼称されるカビ、キノコ、酵母の三つの分類群に分けられています。カビの多くは菌糸と呼ばれる糸状の細胞で形成され、胞子で増えます。カビは一定の環境条件下で発生し、発育に良い環境下では爆発的に増えます。また、カビにはいくつかの種類があり、それぞれ発生する環境や条件が異なります。
住環境においてカビは風呂場や水廻りだけでなく、天井、壁、押し入れ、調度品、食品等のほか様々な場所やものに発生します。カビが発生したものは劣化したり、場合によっては人体に重大な疾患を及ぼす場合があります。
住環境で見られるカビには以下のようなものがあります。
写真提供:麻布大学 生命・環境科学部
| 一般名 | クロカビ | ススカビ | アカカビ |
| 真菌 名称 |
クラドスポリウム属 | アルテルナリア属 | フザリウム属 |
| 画 像 | ![]() |
![]() |
![]() |
| 説 明 | カビの色は深緑色や黒色のカビでクロカビといわれています。風呂場、室内、衣類等の住環境だけでなく食品など様々な場所で発生し気管支喘息の原因ともなります。 | カビの色は黄褐色~褐色、または灰色~黒色です。代表的な菌種とし知られているススカビはハウスダストの中、住宅の壁や塗装面に発生し劣化させます。また、食品やプラスチックなどに発生し汚染します。 | カビの色は灰白色や深紅です。綿毛状のコロニーを作ります。湿度の高い環境を好み風呂場などで発生します。また、植物に発生する植物病原菌ですが発生した植物(麦等)を食べると中毒を発生させます。 |
| 一般名 | 黒色酵母菌 | アオカビ | コウジカビ |
| 真菌 名称 |
アウレオバシジウム属 | ペニシリウム属 | アスペルルギルス属 |
| 画 像 | ![]() |
![]() |
![]() |
| 説 明 | カビの色は発生初期には白色で次第に黒色になります。清涼飲料水、ゼリー、寒天(ところてん)などに発生します。 | カビの色は黄緑色です。ミカンや餅などに発生し“アオカビ”と呼ばれており、革製品を劣化させるカビとして知られています。空気中や土壌などの環境に普通に存在しています。抗生物質のペニシリンやチーズをつくるカビとしても知られています。 | カビの色は黄色~黄褐色。または灰褐色~黒褐色です。酒、味噌、醤油などの醸造などに利用されています。ただし、それ以外の食品などに発生した場合は変質やカビ毒(マイコトキシン)を発生させることがあります。輸入ピーナッツから発がん性があるアフラトキシンが発生したことがあります。 |
| 一般名 | アズキイロカビ | ケタマカビ | ツチアオカビ |
| 真菌 名称 |
ワレミア属 | ケトミウム属 | トリコデルマ属 |
| 画 像 | ![]() |
![]() |
![]() |
| 説 明 | カビの色は褐色~赤茶褐色で小さなコロニーを作ります。比較的乾燥した環境を好み畳や壁などに発生するほか、乾燥食品(魚介類、果物など)、糖分の高い菓子類(羊羹・あんこ等)で発生します。 | カビの色は黄色~黒色です。セルロース分解菌(繊維劣化菌)として知られており、衣類や布製品の品質を劣化し、時にぼろぼろになるまで分解してしまうカビです。 | カビの色は白緑色~緑色です。粉吹き状のコロニーを形成します。他の菌に発生することが多く、この性質を利用して植物病原菌の改良菌としても利用されています。 |
| 一般名 | アスペルギルス・レストリクタス | ミルク腐敗カビ | クロカビ |
| 真菌 名称 |
アスペルギルス・レストリクタス属 | ゲオトリクム属 | エクソフィラ属 |
| 画 像 | ![]() |
![]() |
![]() |
| 説 明 | コウジカビの一種で乾燥した食品などに発生します。乾燥した環境を好みハウスダストの中から多く発見されます。カメラのレンズなどにも発生します。 | カビの色は白色です。湿度の高い環境を好み食品(野菜・果物・豆類・乳製品・食肉・飲料)などを変質させてしまいます。カビ毒はありません。 | カビの色は黒色です。湿度の高い環境を好み、洗濯槽の裏などで発生します。臭いの原因ともなります。また、黒色真菌症の原因ともなります。 |
| 一般名 | ケカビ | カワキコウジカビ | ハンゼヌラ酵母 |
| 真菌 名称 |
ケカビ属 | ユーロチウム属 | ピキア属 |
| 画 像 | ![]() |
![]() |
![]() |
| 説 明 | カビの色は灰白色です。ごく普通に見られ湿った有機物上に発生します。デンプン質や水分の多い食品や果物などに発生し腐敗させます。ケカビは免疫力の弱った人が感染するとムコール症を発症し重篤になることも多いので注意が必要です。 | カビの色は黄色や青緑色です。比較的乾燥した環境を好み、水分が少なく糖分や塩分が高い食品にしばしば発生します。食品以外にも書籍、カメラのレンズ、機械の基盤などにも発生することがあります。 | カビの色は乳白色です。ぬか床、パン、ケーキ、ジュース、シロップ、いなり寿司などに発生します。増殖すると酢酸エチルを生成するのでシンナー臭がします。 |
※表中の画像は分離培養したものです。生活環境で発生したカビは見た目だけでは専門家でも完全に判別することが難しいことがあります。
お問い合わせ、ご相談は、お気軽に当協会事務局へ
03-3254-0014
03-3254-0014